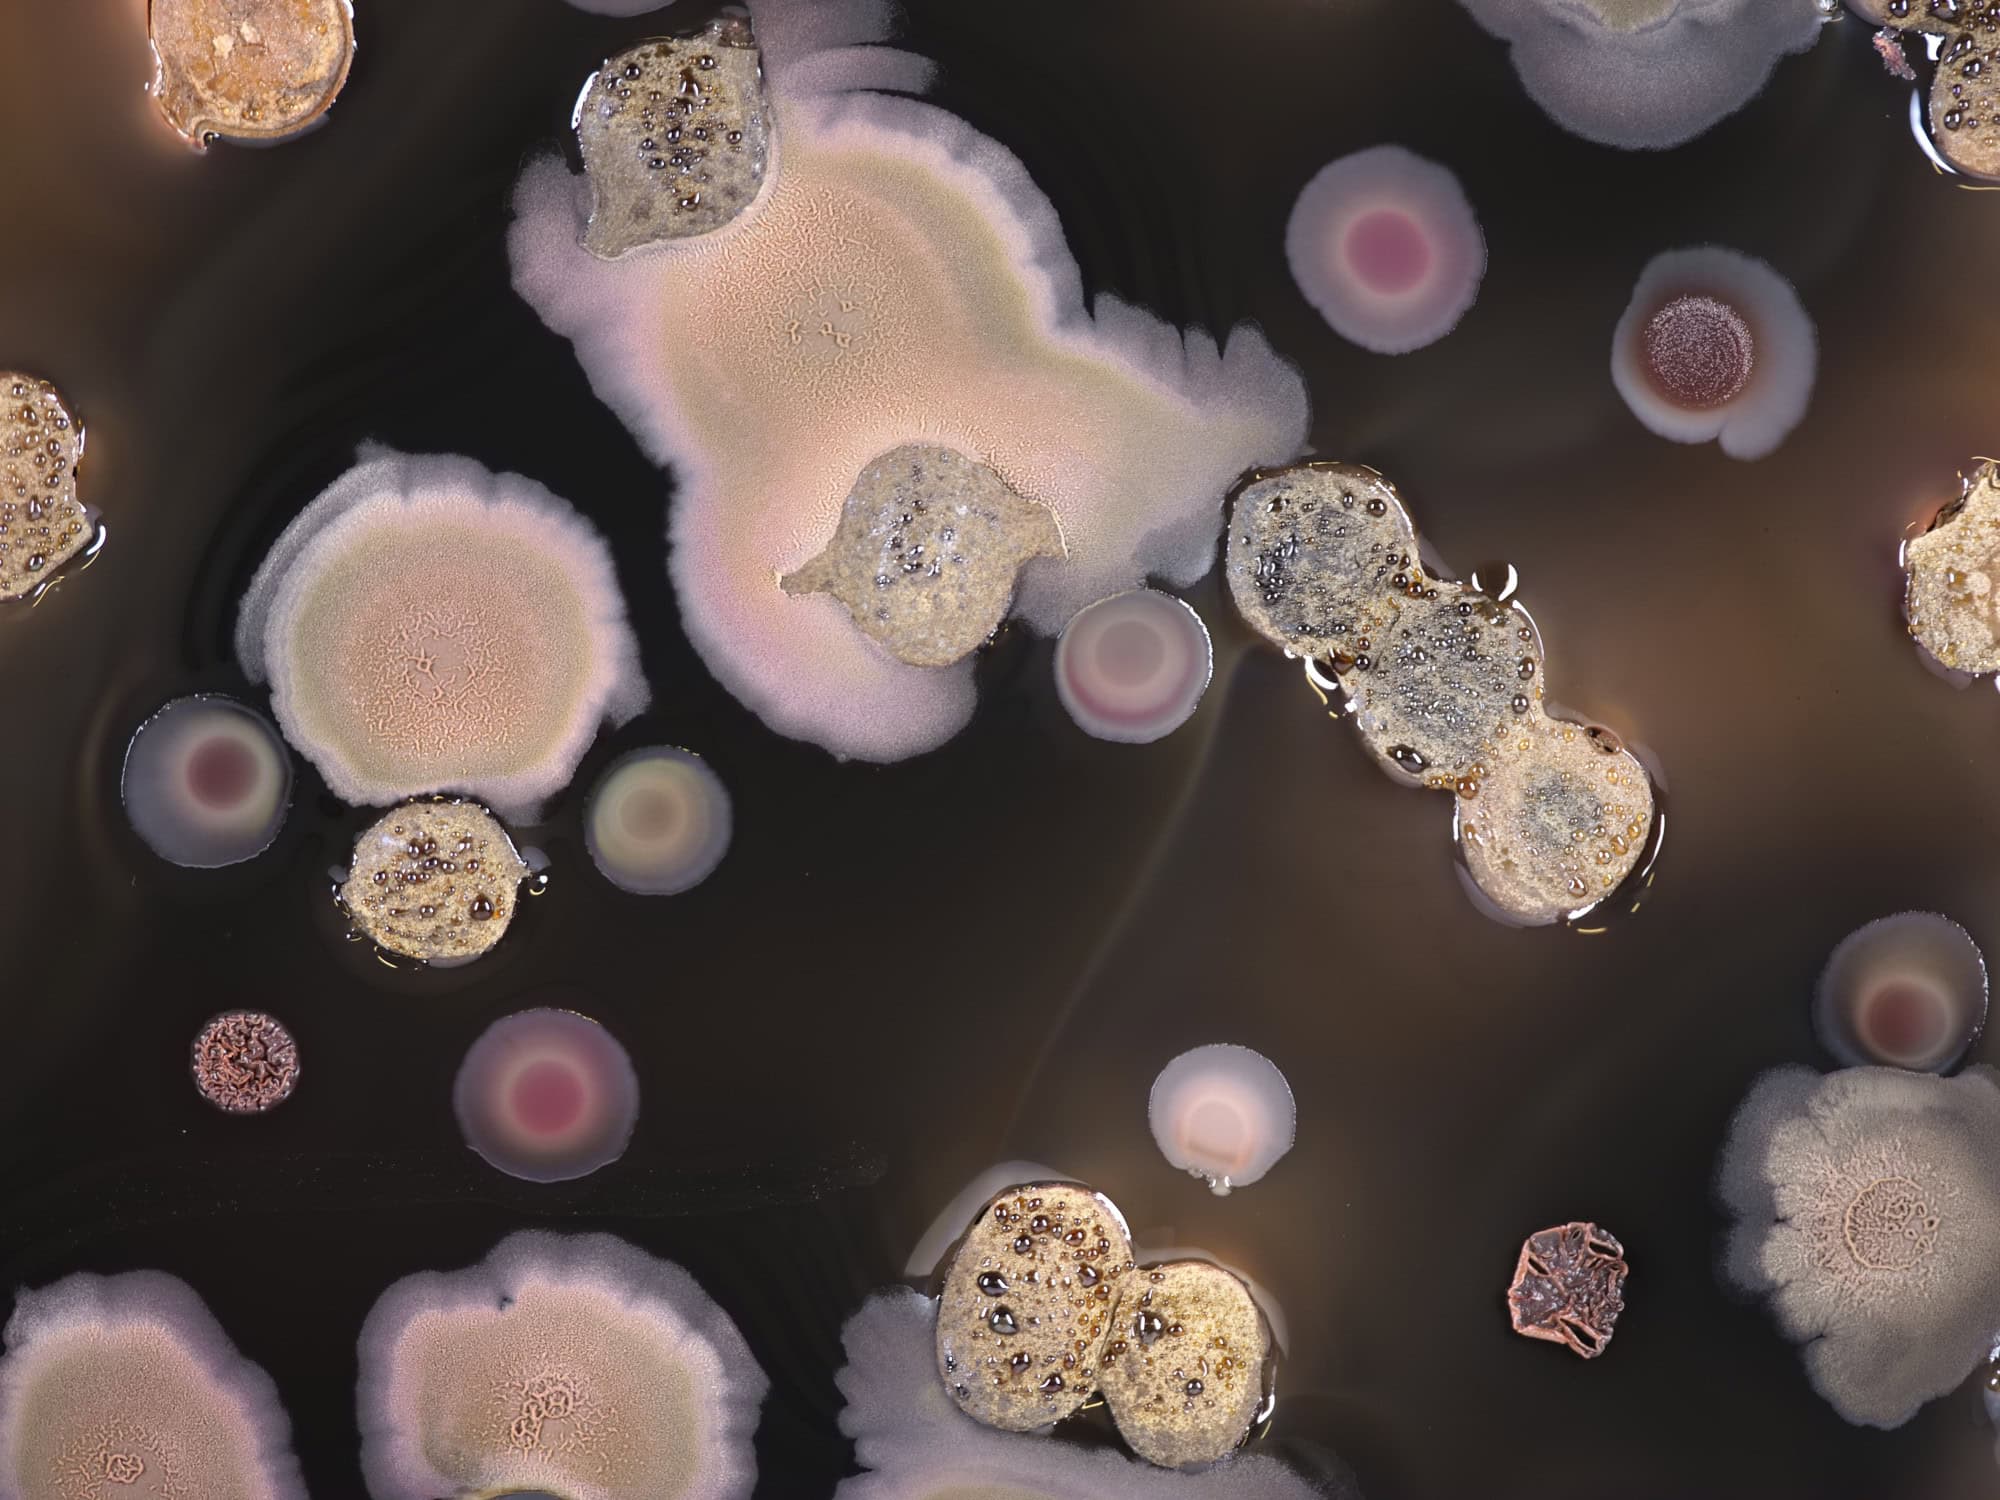
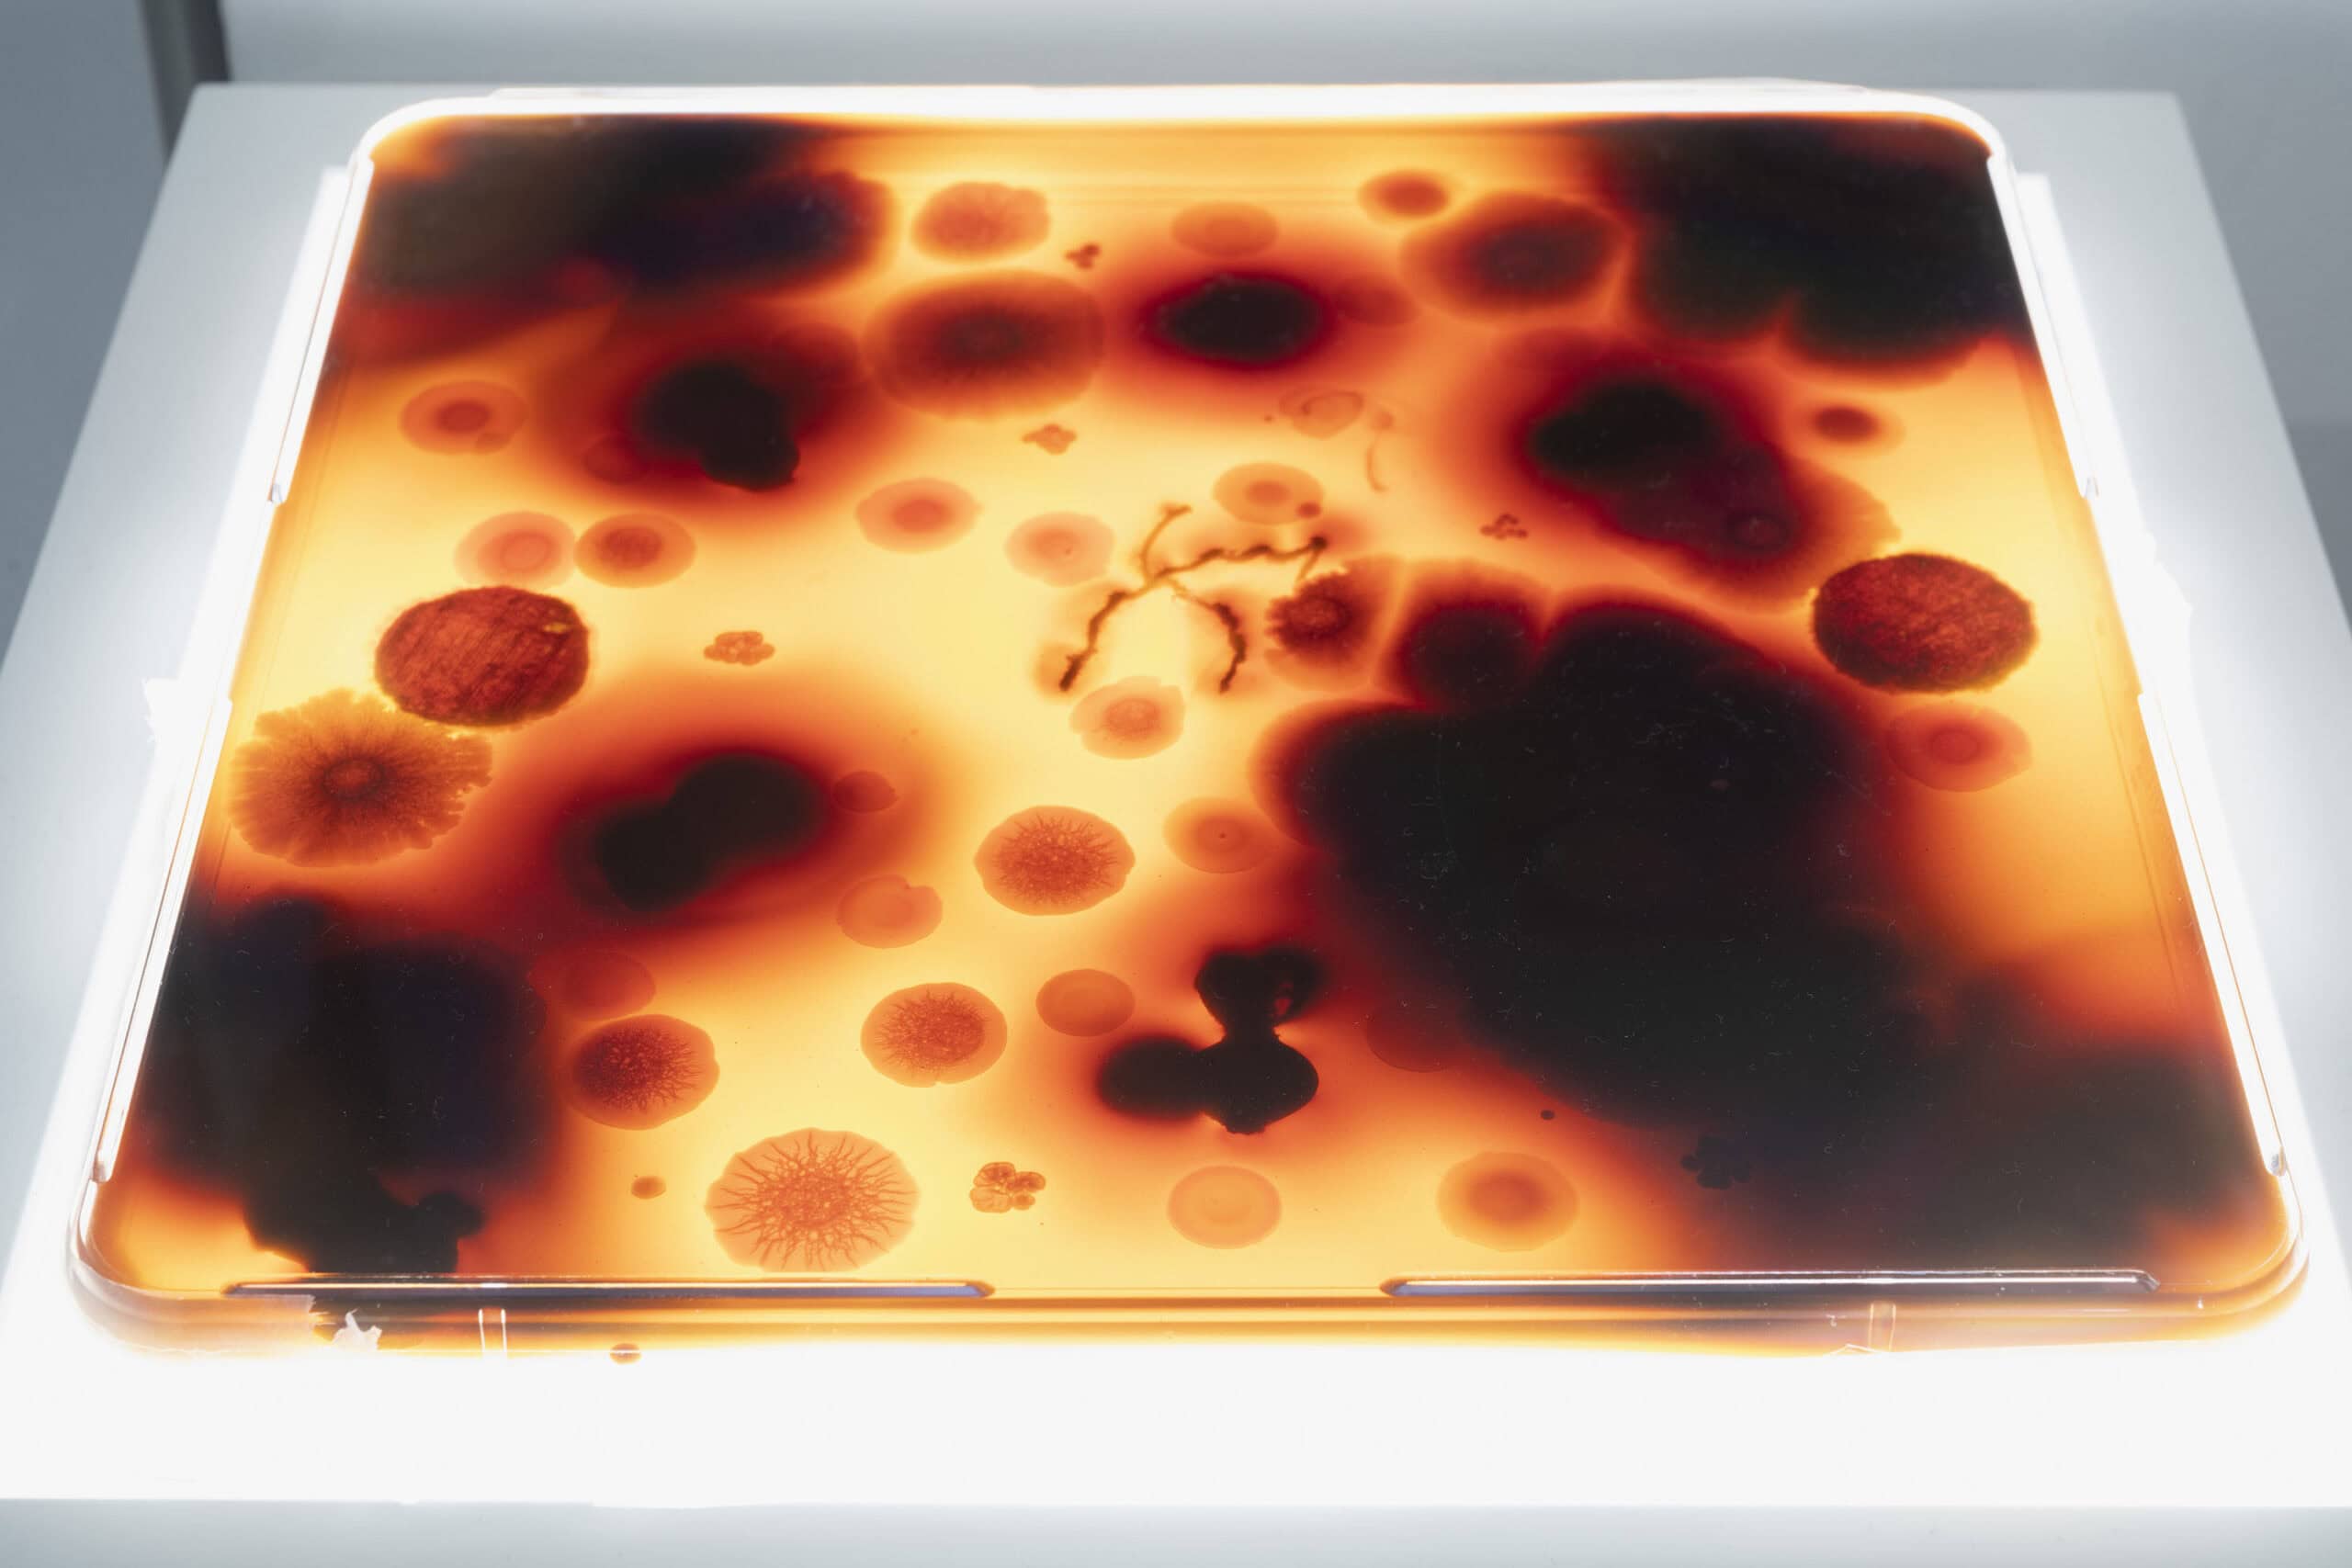

Fermenting Textiles
Weaving Together Traditional Craft, Anthropology, Microbiology, and Art
Adama Séré, Laurence Douny, Regine Hengge, Pauline Agustoni, Satomi Minoshima
Fermenting Textiles ist ein inter- und transdisziplinäres Forschungs- und Ausstellungsprojekt, das die aktive Materie in den Mittelpunkt stellt: Es verbindet Anthropologie, Mikrobiologie und Kunst mit Beiträgen von Kunsthandwerker:innen, Anthropolog:innen, Naturwissenschaftler:innen und Künstler:innen sowie mehr-als-menschlichen Akteur:innen. Fermenting Textiles erforscht die Fermentierung von Textilien in Schlamm und Pflanzenmaterial, um komplexe Färbungen für verschiedene Verwendungszwecke herzustellen – von traditionellen Jagdhemden in Burkina Faso bis zum Färben von Kimono-Seide in Japan. Es handelt sich um handwerkliche Verfahren mit faszinierenden traditionellen Verwendungen und Bedeutungen. In beiden Fällen werden natürliche chemische und biologische Prozesse genutzt, um einzigartige ästhetische und medizinische Ergebnisse zu erzielen.
Auch kulturübergreifende Forschungsmethoden spielen bei Fermenting Textiles eine wichtige Rolle. Die Anthropologin Laurence Douny hat mit Kolleg:innen und Färber:innen in Burkina Faso zusammengearbeitet, um den langwierigen Prozess der Vouwo-Schlammfärbung akribisch zu dokumentieren, bei dem Erde unterschiedlicher Herkunft, Eisenerz und verschiedene Pflanzenmaterialien verwendet werden. Die Mikrobiologin Regine Hengge und ihr Doktorand José I. Hernández Lobato haben die komplexen Interaktionen von Bodenbakterien mit Pflanzen und Stoffen im Färbeprozess untersucht und stellen diese in der Ausstellung visuell nach. Darüber hinaus schafft Hengge fächerübergreifend fotografische Muster, die Bilder von bakteriellen Biofilmen aus dieser wissenschaftlichen Forschung mit den von Douny untersuchten westafrikanischen Textilien kombinieren. Diese wurden auf Stoffe für die Herstellung neuer Hemden gedruckt und vervollständigen so eine transdisziplinäre Reise von „shirt to shirt“.
Das Kunst- und Designprojekt Craft Portrait: Dorozome von Pauline Agustoni und Satomi Minoshima untersucht das Färben von Stoffen durch Kunsthandwerker:innen auf der südjapanischen Insel Amami Oshima. Traditionell werden die Seidenfäden für die Kimonoherstellung, die mit Baumwollfäden verwoben sind, zunächst in einem flüssigen Bad aus Baumrinde gefärbt. Anschließend werden sie wiederholt in Schlamm getaucht, bevor die Baumwollfäden entfernt werden, um die ungefärbten Teile des Stoffes freizulegen. Dabei kommt es zu chemischen Reaktionen der Komplexbildung und Oxidation, die zu satten dunkelbraunen und schwarzen Seiden führen. In Zusammenarbeit mit den Kunsthandwerker:innen in Japan haben Agustoni und Minoshima eine Textilskulptur aus rosa-braunen und schwarzen Fäden hergestellt, die sich drehen und winden und so den Akt des Auswringens nachahmen, der ein wesentlicher Bestandteil des Färbeprozesses ist.
Durch die Kombination dieser Ansätze, Methoden und Kontexte unterstreicht Fermenting Textiles das Wirken und die Empfindungsfähigkeit der Materie im Fermentationsprozess und ihre vielseitige Materialität. Aus der Perspektive posthumanistischer Philosophie betrachtet, tritt die Materie aktiv auf, was die Philosophin Karen Barad als „eine materialistische, naturalistische und posthumanistische Ausarbeitung“ beschreibt, „die der Materie den ihr gebührenden Platz als aktive Teilnehmerin am Werden der Welt, an ihrer fortwährenden ‚Intra-Aktivität‘ einräumt“ (Barad 2003). Die einzigartige multinationale, multi- und transdisziplinäre Zusammenarbeit, aus der die Gruppenausstellung Fermenting Textiles besteht, spiegelt die artenübergreifende Kollaboration wider, die ein wesentlicher Bestandteil des Färbeprozesses von Schlamm ist.
Regine Rapp & Christian de Lutz
Literatur im Kontext
Douny, L., Hernández Lobato, J.I., Séré, A., Sawadogo, S. and Hengge, R. (2023). The hunter shirt: the role of Acacia nilotica in fermentative textile dyeing. Acta Hortic. 1361, 67-76, DOI: 10.17660/ActaHortic.2023.1361.8.
Douny, L., Hengge, R., Hernández Lóbato, J.I., Rapp, R. & de Lutz, C (2025) Fermenting Textiles: the Hunter Shirt. In: Abschlusspublikation des Exzellenz-Clusters Matters of Activity (in Vorbereitung, publiziert bei Birkhäuser).
Douny L, Lobato JIH, Amini S, Séré A, Sawadogo S, Fratzl P, Hengge R (2025) Vouwo mud dye: A material, microbiological and cultural approach to researching sustainable textile dyes. Coloration Technology. 1-12. doi:10.1111/cote.12824
Mehr Informationen:
https://www.matters-of-activity.de/en/posts/16004/fermenting-textiles
https://www.matters-of-activity.de/en/research/projects/55/weaving
https://www.matters-of-activity.de/en/
Die Ausstellung „Fermenting Textiles“ ist auch Teil des __matter FESTIVAL 2025, das vom Exzellenzcluster Matters of Activity. Image Space Material der Humboldt-Universität zu Berlin organisiert wird.
Adama Séré ist ein Marka-Dafing-Färbermeister, traditioneller Heiler und Vorsitzender der Jägervereinigung Batônôtiban in der Region Mouhoun in Burkina Faso. Er stammt aus dem Dorf Safané und hat von seinem Vater Passourou Séré das Handwerk des Färbens von Jagdkleidung mit Heilpflanzen und Schlamm, bekannt als Vouwo, für häusliche und zeremonielle Zwecke geerbt. Mit über 50 Jahren Erfahrung im Färben von Textilien hat Adama an dem Projekt „Hunter Shirt“ mit Forscher:innen des Exzellenzclusters „Matters of Activity. Image Space Material“ an der Humboldt-Universität zu Berlin zusammengearbeitet. In diesem transdisziplinären Projekt führte Adama eine Reihe von handwerklichen Experimenten vor Ort durch, bei denen er verschiedene Schlammfärberezepte auf Baumwollstoffe auftrug, um die Farbherstellung zu erkunden und gleichzeitig die nachhaltige Dimension seiner Kunst zu demonstrieren.
Dr. Laurence Douny ist wissenschaftliche Mitarbeiterin am Exzellenzcluster „Matters of Activity. Image Space Material“ an der Humboldt-Universität zu Berlin und beschäftigt sich mit der Herstellung von Textilien in Westafrika aus der Perspektive einer Anthropologie der Materialien, Techniken und Umgebungen. Mit einem feldforschungsbasierten und speziesübergreifenden Ansatz untersucht sie die materiellen und kulturellen Eigenschaften von Wildseidenstoffen und deren Ersatzstoffen durch komplexe fermentative Färbetechniken. Ihre Forschung zu fermentierten Textilien beleuchtet die jahrhundertealte Kunst der Faserveredelung im Kontext der Nachhaltigkeit, die auf der Zusammenarbeit mit Kunsthandwerker:innen, Mikrobiolog:innen und Materialwissenschaftler:innen basiert. Douny ist Mitglied des Lenkungsausschusses von ArtBioMatters (ABM) (NYU/The Met) und Forschungsmitglied des Projekts WILDSILKS, das von der französischen Agence Nationale de la Recherche (ANR) finanziert wird. Kürzlich hat sie zusammen mit Marka-Dafing-Kunsthandwerker:innen aus Burkina Faso die Dokumentation der Wildseidenproduktion durchgeführt, die vom Endangered Material Knowledge Program (EMKP)/Arcadia Fund des British Museum finanziert wurde.
Prof. Dr. Regine Hengge, Professorin für Mikrobiologie an der Humboldt Universität zu Berlin, leistete Pionierarbeit zum Überleben von Bakterien unter Stressbedingungen, insbesondere zu molekularer Signalverarbeitung und Regulation sowie zur komplexen Architektur und Morphogenese von bakteriellen Biofilmen. Im Exzellenzcluster Matters of Activity erforscht sie Stoffe und Formen des Lebens an den Schnittstellen von Wissenschaft und Kunst – von bakterieller Cellulose als selbst-wachsendes lebendes Material für Design über fermentative Textilfärbung bis zu visuellen re-enactments der Interaktionen von Pflanzen und Mikroben in Kunstprojekten. Ausgehend von anthropologischen, historischen und molekular-mikrobiologischen Untersuchungen von traditionellen medizinischen und handwerklichen Praktiken, entwickelte sie das Konzept der Menschlichen Kuration von Multi-Spezies-Interaktionen als Basis für nachhaltigere Technologien. Für ihre Forschungen erhielt sie den Gottfried-Wilhelm-Leibniz-Preis und einen ERC Advanced Investigator Grant. Sie ist gewähltes Mitglied der Leopoldina, von EMBO und anderen wissenschaftlichen Akademien.
Pauline Agustoni ist eine Schweizer Künstlerin und Designerin. An der Schnittstelle von konzeptionellem Design und Kunst erforscht ihre Arbeit die Poesie der Begegnungen zwischen Materialien, Techniken und Gesten der Herstellung. Seit ihrem Abschluss an der Design Academy Eindhoven erforscht sie, wie sehr wir mit den Waren, die wir gestalten, verflochten sind und wie diese uns im Gegenzug formen. Indem sie in Produktionsräume und -prozesse eintaucht, stellt sie Momente des Austauschs – mit Menschen und Materialien – in den Mittelpunkt ihrer Praxis. Durch ihre Projekte, seien es Installationen, Publikationen oder Objektserien, fördert sie ein erhöhtes Bewusstsein für die Gesten und Techniken, die unsere materielle Welt formen. Ihre Erfahrungen reichen von dem Gemeinschaftsprojekt „Craft Portrait“, einer Keramik-Residency am EKWC, der freiberuflichen Arbeit für die Designerin Hella Jongerius bis hin zu Ausstellungen bei den Swiss Design Awards in Basel, dem Atelier MUJI Ginza in Tokio und dem Nieuwe Instituut in Rotterdam.
Die japanische Designerin Satomi Minoshima untersucht die Möglichkeiten verschiedener Materialien und Farben. Sie versucht, den einzigartigen Kontext zu verstehen, der bestimmte Farben und Materialien umgibt, was zu einer neuen Interpretation und Perspektive ihres Entstehungsprozesses führt. Indem sie stets die Greifbarkeit des Objekts ehrt, verbindet Minoshimas Designansatz materialbasierte Forschung mit einer echten und poetischen Erzählung, um ihre Konzepte zum Leben zu erwecken. Sie besitzt Abschlüsse der Musashino Art University in Tokio (2014) und der Design Academy Eindhoven (2019) und hat ihre Arbeiten international ausgestellt. Sie lebt derzeit in den Niederlanden und wurde 2022 mit dem Raising Talent Awards Japan von Maison & Objet ausgezeichnet.
Presse Feedback
„Biologische Materialien sind oder waren zumindest Lebewesen – und Leben bedeutet Aktivität“. Interview mit Mikrobiologin Regine Hengge, von Kristina Vaillant, Presse-Portal, Humboldt Universität Berlin (13. Mai 2025)
Funktionskleidung aus Schlamm und Bakterien: Berliner erforschen nachhaltige Textilien aus Westafrika, im Tagesspiegel von Martin Ballaschk (22. Mai 2026)
‘Fermenting Textiles’, an intimate portrait of the act of mud-dyeing fabrics that opens a dialogue in the field of fabric colouring, bei CLOT Magazine London von Juliette Wallace (26. Mai 2025)
Fermentiertes Wissen, in der taz von Brigitte Werneburg (10. Juni 2025)